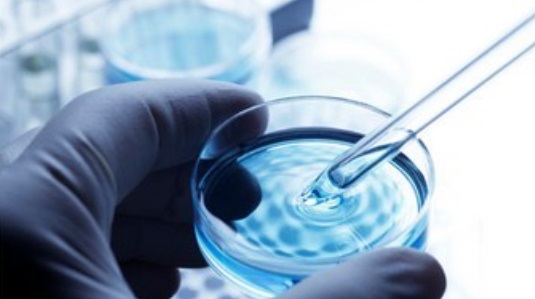
6f3689d4ec4f2fcb69f4c58ccbc5baea_1448497531_6.jpg 6f3689d4ec4f2fcb69f4c58ccbc5baea_1448497531_6.jpg

분석/연구용역 간편상담
담당 연구원 확인 후
연락드리겠습니다.
24시간동안 이 창을 열지않음
분석/연구용역 간편상담
담당 연구원 확인 후
연락드리겠습니다.
24시간동안 이 창을 열지않음
공지사항
생명공학 분야의 선두주자로서 신뢰성 있는 연구성과를 제공합니다.유인균 장내 세균 분석 검사 CRO 신약 개발 임상 시험
작성자관리자
본문

한국의과학연구원이 신약 개발 CRO(Contract Research Organization, 임상시험수탁)
SERVICES 및 유전체 분석 전문 연구를 수행한다.
인간유전체와 `세컨지놈(second genome)`이라 불리는 유전체 기반의 마이크로바이옴
분석 관련 연구를 전문으로 진행하는 한국의과학연구원은 Metagenomics and
Microbiome Research 분야에 차별화된 기술을 보유한 의료과학연구소 이다.
한국의과학연구원은 유전체 기술을 이용한 마이크로바이옴 분석 전문 연구소로서,
휴먼마이크로바이옴 프로젝트에 선도적 역할을 주도하고 있다.
개인 특이적 다양성을 가진 인체 공생 마이크로바이옴 특성 규명을 통한
인체-마이크로바이옴 상호작용, 건강과 질환에 직접 연관되어 면역질환 등
다양한 질환 치료 관련 대규모 마이크로바이옴 유전체 분석
데이터를 축적해 나가고 있다.

마이크로바이옴관련 연구는 인간 유전체연구에 한 영역으로서 인간의 몸속에 있는
미생물의 분포를 통하여 인체 질환의 위험도를 예측하는 기술로서 임상영역의
진단부분 및 질병의 치료제 개발과 질병 예측진단에 많은 유용성이 있다.
특히 최근 신약개발 단계에 유전적, 환경적 요인에 따른 약효의 개인차를 극복하기
위한 많은 연구들이 진행되고 있으며, 특정 환자군에 적합한 치료제 개발의 중요성이
부각되고 있다.
이와 더불어 개인맞춤형 마이크로바이옴연구는 미래유망기술로 부각되고 있다.
한국의과학연구원은 우수한 기술력과 거대한 인프라를 기반으로 신약개발
CRO(Contract Research Organization, 임상시험수탁) 연구 영역과 관련하여 맞춤형
신약개발을 위한 약물유전체학의 선진화된 연구로
"유전체 기반의 개인맞춤형 의료 분야의 `예방의학의 통합솔루션`데이터베이스 구축
연구를 수행하고 있다.
국내 신약 개발 및 의료기관에서의 환자 치료에 한층 진일보된 연구 데이터베이스
구축으로 우리나라의 세계 의료과학 강국 진입에 선도적 역할을 수행해 나가고 있다.